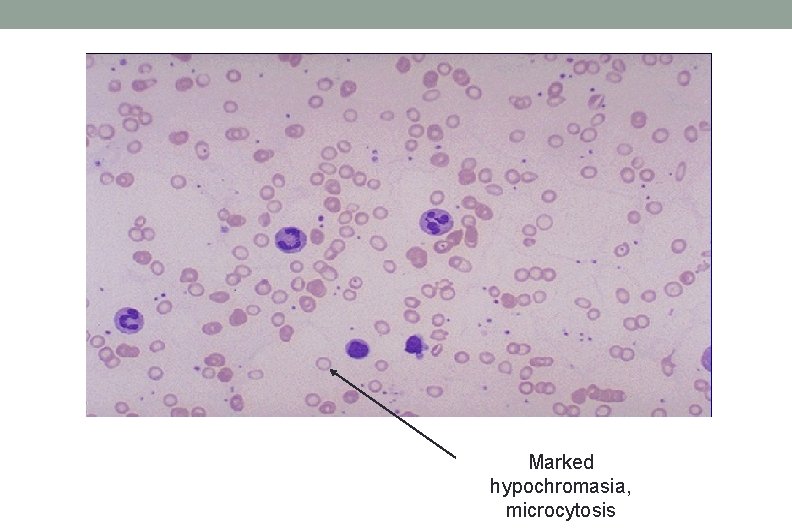
Marked hypochromasia, microcytosis Marked hypochromasia, microcytosis

IRON DEFICIENCY ANEMIA Rakhi Naik MD MHS Assistant

- Slides: 42
IRON DEFICIENCY ANEMIA Rakhi Naik, MD, MHS Assistant Professor of Medicine & Oncology, Division of Hematology
Disclosures None
Objectives • Understand the basic physiology of iron absorption, transport and storage • Understand the causes of iron deficiency and the compensatory responses seen in clinical lab tests • Understand modalities of treatment of iron deficiency and anemia
Global Burden of Anemia KASSEBAUM et al BLOOD, 30 JANUARY 2014 x VOLUME 123, NUMBER 5
KASSEBAUM et al BLOOD, 30 JANUARY 2014 x VOLUME 123, NUMBER 5
KASSEBAUM et al BLOOD, 30 JANUARY 2014 x VOLUME 123, NUMBER 5
Iron Distribution Adult male has ~4 g total body iron stores Andrews NEJM, 23 DEC 1999 x VOLUME 341, Number 26
Hemoglobin in RBC Heme is a porphyrin ring containing an iron atom Each Hgb molecule can bind 4 oxygen molecules at heme site Schechter BLOOD, 15 NOVEMBER 2008 112, NUMBER Schechter BLOOD, 15 VOLUME NOVEMBER 2008 VOLUME 10 112, NUMBER 10
Iron Absorption • Food sources supply: 10 - 25 mg / day • Absorbed in the brush border of the upper small intestine • Enhanced by gastric acid • Inhibited by tannins, systemic inflammation • Most dietary iron is nonheme form, <5% bioavailability • < 10% dietary iron is heme form, >25% bioavailability
Iron absorption from food Rice Spinach Black beans Corn Lettuce Wheat Soy beans Ferritin Veal liver Fish muscle Hemoglobin Veal muscle Non-heme iron Heme iron 0 5 10 15 20 Iron Absorption (% of dose) 25
• Transferrin – plasma iron transporter protein. Carries less than 1% of total body iron • Ferritin – intracellular storage of iron • Hemosiderin – long term iron storage pool
Iron Storage • Ferritin • Hemosiderin • multi-subunit protein • insoluble form of ferritin • primarily intracellular • visible microscopically • some in plasma
The iron cycle Pietrangelo, NEJM 2004: 350: 2383
Iron Losses • Iron is closely conserved in humans <0. 05% of iron is lost per day normally 1. Very small amounts in urine, bile and sweat 2. Cells shed from skin, intestinal and urinary tracts 3. Menstrual blood loss 4. Pregnancy and lactation • Humans have NO other physiologic means to excrete excess iron
Pathogenesis of Iron Deficiency • Blood loss • Occult or overt GI losses, traumatic or surgical losses • Failure to meet increased requirements • Rapid growth in infancy and adolescence • Menstruation, pregnancy • Inadequate iron absorption • Diet low in heme iron • Gastrointestinal disease or surgery • Excessive cow’s milk intake in infants
Andrews NEJM, 23 DEC 1999 x VOLUME 341, Number 26
Features of Iron Deficiency Anemia • Depends on the degree and the rate of development of anemia • Symptoms common to all anemias: • pallor, fatigability, weakness, dizziness, irritability
Other features of IDA • Pagophagia - craving ice • Pica - craving of nonfood substances • e. g. , dirt, clay, laundry starch • Glossitis - smooth tongue • Restless Legs • angular stomatitis - cracking of corners of mouth • Koilonychia - thin, brittle, spoon-shaped fingernails
Tests for Iron Deficiency • Peripheral blood smear • Red cell indices (MCV, MCH) • Serum ferritin • Serum iron / transferrin = iron saturation • Bone marrow iron stain (Prussian blue)
Marked hypochromasia, microcytosis
Bone Marrow Circulation High s. Tf. R Low Hgb N Reticulocyte N Erythroblast Tf. R+ N Erythrocyte Iron Deficiency Fe Transferrin Low Serum Fe/TS Serum Macrophage Low s. Ft/Liver Fe Spleen
Sequential Changes in IDA NORMAL DEPLETED IRON STORES FERRITIN IRON SATURATION MCV & Hb & Hct IRON DEFICIENCY ANEMIA
Differential for low serum ferritin 1. 2. Iron Deficiency
CBC in Iron Deficiency Anemia
Lab values in severe IDA
Differential Diagnosis of IDA • Thalassemia trait (low MCV, normal RDW) • Imbalance of globin chain production • Anemia of inflammation • Decreased iron utilization in the face of adequate iron stores • Low ferritin / serum transferrin receptor
IDA vs. Inflammation IDA Inflammation Ferritin Serum Iron Transferrin sat sf. TR / log Ferr Marrow Iron No D
Punnonen, K, Blood 1997; 89: 1052 Tf. R-ferritin index <1. 0 suggests the diagnosis of ACD, while an index >2. 0 suggests either IDA or the combination of IDA and ACD
Iron stain of bone marrow Normal Marrow Prussian Blue Stain Iron Deficient Marrow Prussian Blue Stain
Treatment • Most patients are treated initally with oral iron unless there is an absorptive problem. • Dietary sources + Fe. So 4 BID. • TID is very constipating and causes gastric distress; commonest cause for noncompliance • Iv iron is no longer ‘dangerous’. The newer formulations such as iron sucrose, lmw iron dextran and ferric gluconate have minimal risks of infusion reactions • In very severe cases, RBC transfusion
Oral Therapy of Iron Deficiency • Carbonyl iron (elemental), heme-iron polypeptide (extracted from porcine RBC), polysaccharide-iron complex • Ascorbic acid increases oral iron absorption but dose is usually not in significant quantity to make a difference • Phytates (cereal grains), tannins (tea) and antacid therapy inhibit oral iron absorption
Journal of Family Practice JUNE 2002 VOL. 51, NO. 6 Price Matters!
Response to oral Iron Therapy • Peak reticulocyte count 7 - 10 d. • Increased Hb and Hct 14 - 21 d. • Normal Hb and Hct 2 months • Normal iron stores 4 - 5 months
Hgb response and MCV response parallel each other after iron replacement
Indications for iv iron • Severe symptomatic anemia requiring accelerated erythropoesis • Failure of oral iron from g. i intolerance • Failure of oral iron due to absorption issues ØH pylori infection, autoimmune gastritis, celiac disease, gastric bypass surgery, inflammatory bowel disease • Cancer and chemotherapy associated anemia • Anemia with chronic renal disease (with or without[? ] dialysis dependance) • Heavy ongoing g. i or menstrual blood losses Bastit et al JCO 26: 1511 -1618 2008 Henry et al The Oncologist 2007; 12: 231– 242
Intravenous Iron formulations • High molecular weight Iron Dextran is not routinely used anymore due to a much poorer safety profile (anaphalyctoid reactions) in comparison to newer iron preparations • Hemoglobin iron deficit (mg) = Body Wt x (14 - Hgb) x (2. 145) • (formula dose not account for repletion of body stores)
Lmw Iron Dextran Iron Sucrose Ferric Gluconate Ferumoxytol Ferric Carboxy maltose 100 mg 200 mg 125 mg 510 mg 750 mg 1000 mg no no 1020 mg 3 d apart 1500 mg 7 d apart Inexpensive IDA in CKD/HD +epo Test dose Yes none Administration Iv (preferred) or im Iv push or 15 m infusion i. v push or 1 hr infusion Administered Dosage Total Dose Infusion Cost Indication Inexpensive Expensive IDA in CKD None Expensive IDA + IDA in CKD None 17 s i. v push or 7. 5 m iv push or 15 m infusion
Iv iron for fatigued nonanemic women with serum ferritin <15 mg/dl BLOOD, 22 SEPTEMBER 2011 VOLUME 118, NUMBER 12
In Conclusion…. • IDA is a highly prevalent, but easily treatable condition • Oral iron therapies are mostly equivalent in efficacy • Infusion reaction rates are very low in iv iron products other than HMW dextran • Costs and indication for therapy are important to help decide the best iv iron replacement product for a patient.
Iron studies in inflammation and CKD • There is no established goal as to what lab parameters are considered iron deficiency • Functional iron deficiency is where iron stores are present in the body but not usable due to Hepcidin • Usually normocytic but microcytic anemia in severe cases
Iron deficiency in inflammation and CKD Transferrin sats % Ferritin Inflammation <20% <100 CKD <20% <100 ESRD <30% <500
Questions rakhi@jhmi. edu